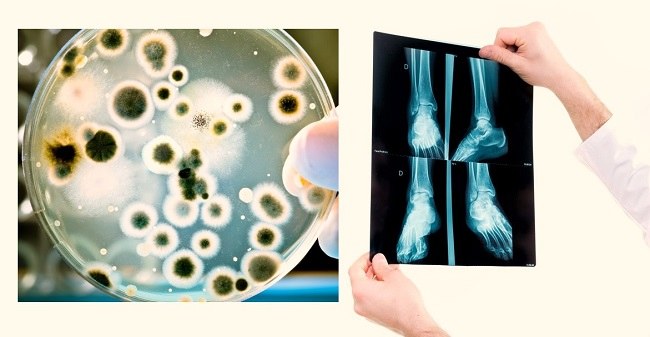
Depositphotos_19679985_m-2015_compressed

Pemeriksaan imaging dan kultur darah tidak direkomendasikan pada selulitis. Pada selulitis, beberapa pemeriksaan penunjang sering dilakukan, contohnya kultur darah, swab mikro, dan pemeriksaan pencitraan seperti USG dan CT scan. Pemeriksaan ini mungkin berguna untuk mengetahui bakteria kausal dan adanya komplikasi. Namun, ada beberapa studi terbaru yang mempertanyakan kegunaan pemeriksaan-pemeriksaan ini untuk pasien selulitis.
Selulitis merupakan inflamasi non nekrotik yang mengenai kulit dan jaringan sub kutan, biasanya disebabkan oleh infeksi akut dari bakteri kelompok Streptococcus, methicilin-susceptible Staphylococcus aureus (MSSA) dan methicilin-resistant Staphylococcus aureus (MRSA). Selulitis biasanya ditandai dengan adanya eritema, nyeri, bengkak dan terasa hangat pada bagian kulit yang terinfeksi. Di Amerika Serikat terdapat sekitar 14,5 juta kasus selulitis setiap tahunnya, dan 650,000 kasus diantaranya membutuhkan perawatan di Rumah Sakit.[1-3]
Rekomendasi Evaluasi dan Terapi Selulitis
The Infectious Disease Society of America atau IDSA memberikan rekomendasi terbaru yang dikeluarkan pada tahun 2014 mengenai evaluasi dan terapi pada selulitis. Kultur darah atau aspirasi kutaneus, biopsi, maupun swab tidak direkomendasikan secara rutin.
Kultur darah, kultur aspirasi kutaneus, biopsi atau swab direkomendasikan pada pasien kanker dengan kemoterapi, demam neutropenia, imunodefisiensi, trauma dan digigit hewan.
Kasus selulitis yang tidak disertai gejala infeksi sistemik ditatalaksana dengan antibiotik yang adekuat melawan bakteri Streptococcus. Pada kasus selulitis dengan gejala infeksi sistemik dapat diberikan antibiotik yang dapat melawan bakteri MSSA. Pada pasien selulitis yang berhubungan dengan trauma dan memiliki kolonisasi MRSA pada nasal dapat diberikan antibiotik yang dapat melawan MRSA seperti Vankomisin. Pada pasien dengan imunodefisiensi berat dapat diberikan terapi empiris infeksi berat yaitu gabungan vankomisin dan piperasilin-tazobaktam atau imipenem/meropenem.
Rekomendasi terapi antibiotik adalah 5 hari dan dapat diperpanjang sesuai dengan kondisi klinis. Elevasikan bagian tubuh yang terinfeksi dan berikan terapi untuk faktor predisposisi seperti edema.
Pada selulitis ekstremitas inferior, klinisi harus melakukan pemeriksaan secara hati-hati pada celah antar jari kaki karena dengan menerapi fisura atau maserasi dapat mengeradikasi kolonisasi patogen dan mengurangi insidensi rekurensi infeksi.
Pemberian terapi dapat dilakukan secara poliklinis bila tidak ada infeksi sistemik atau instabilitas hemodinamik. Pasien dapat dirawat inap bila terdapat infeksi yang lebih dalam, nekrosis jaringan, respon terapi yang kurang baik atau pasien dengan imunosupresan.[4]
Pemeriksaan Pencitraan pada Selulitis
Selulitis biasanya dapat didiagnosis berdasarkan gejala klinis, walaupun begitu pemeriksaan pencitraan (imaging) dapat membantu mengidentifikasi perluasan penyakit dan mengeksklusi kondisi lain yang lebih serius seperti abses, miositis dan fascitis nekrosis.[5]
Pemeriksaan radiografi atau X-ray merupakan pilihan pertama, walaupun hasilnya tidak spesifik. Pada pemeriksaan radiografi selulitis biasanya menunjukkan pembengkakan sampai lapisan sub kutan. Pemeriksaan radiografi dapat mengeksklusi adanya benda asing atau kondisi patologis lain yang tidak diperkirakan sebelumnya.
Bila diduga terjadi infeksi yang lebih serius, maka pemeriksaan magnetic resonance imaging (MRI) dapat dipertimbangkan karena dapat memvisualisasikan jaringan lunak serta mengidentifikasi cairan patologi dengan lebih baik. Pada pemeriksaan MRI, selulitis terlihat sebagai area hipodens yang fokal maupun difus.[6]
Computed Tomography (CT) scan dapat menjadi alternatif dari pemeriksaan MRI. Pemeriksaan CT scan pada selulitis menunjukkan penebalan kulit dan peningkatan penampakan lemak subkutan. Ultrasonografi (USG) memiliki peran terbatas dalam pemeriksaan selulitis sehingga jarang digunakan. Pemeriksaan USG pada selulitis menunjukkan adanya penebalan kulit, edema subkutan dan cairan pada septum lobulus. USG biasanya digunakan untuk mengeksklusi deep vein thrombosis (DVT) atau abses jaringan lunak.[7,8]
Studi Manfaat Pemeriksaan Pencitraan dan Kultur Darah pada Selulitis
Walaupun IDSA tidak merekomendasikan pemeriksaan pencitraan pada pasien selulitis tanpa demam neutropenia, dan tidak merekomendasikan kultur darah pada pasien selulitis tanpa imunodefisiensi atau tanpa luka gigitan hewan,[4] tetapi masih banyak klinisi yang melakukan pemeriksaan penunjang tersebut pada pasien selulitis tanpa komplikasi.
Sebuah studi berupa studi kohort prospektif dengan jumlah subjek yang cukup besar melaporkan bahwa kultur darah dan kultur luka pada pasien dengan infeksi kulit dan jaringan lunak kurang bermanfaat. Studi ini melaporkan bahwa hanya sedikit dari pasien yang dilakukan kultur akan menunjukkan hasil yang positif (low yield), dan dari kultur yang positif tersebut organisme yang ditemukan masih sensitif dengan regimen antibiotik yang digunakan sekarang.[9]
Sebuah studi literatur di tahun 2016 menyimpulkan bahwa diagnosis selulitis yang tanpa komplikasi dan komorbiditas dapat dibuat utamanya dengan anamnesis dan pemeriksaan fisik yang baik, karena kultur darah seringkali kurang bermanfaat. Studi ini juga menyatakan bahwa pemeriksaan pencitraan tidak cukup spesifik untuk selulitis, namun dapat membantu membedakan selulitis dengan diagnosis banding lain.[3]
Sebuah studi kohort retrospektif lainnya dilakukan untuk menilai manfaat pemeriksaan penunjang pada selulitis secara klinis serta mengestimasi biaya pemeriksaan penunjang yang harus dikeluarkan pada pasien yang didiagnosis selulitis tanpa komplikasi.[10]
Studi tersebut melibatkan 183 pasien selulitis tanpa komplikasi yang dirawat di Massachussetts General Hospital dalam rentang waktu kurang lebih 3 tahun yaitu dari tahun 2014 sampai tahun 2017. Dari 183 pasien selulitis tanpa komplikasi, 60 (32.8%) diantaranya menjalani pemeriksaan kultur darah dan hasil kultur tersebut hanya positif pada 1 (1.7%) pasien.
Setelah peneliti melakukan analisa, didapatkan bahwa hanya 18 (10%) pasien yang layak melakukan kultur darah berdasarkan pedoman IDSA. Sebanyak 124 (67,8%) pasien menjalani pemeriksaan pencitraan (imaging), 83 diantaranya menjalani 1 jenis pemeriksaan pencitraan, 30 pasien menjalani 2 jenis pemeriksaan pencitraan dan sisanya menjalani 3 jenis atau lebih pemeriksaan pencitraan.
Pemeriksaan pencitraan yang dilakukan diantaranya 53 (29%) pasien menjalani pemeriksaan radiografi atau X-ray, 29 (16%) pasien menjalani pemeriksaan CT-scan dan 11 (6%) pasien menjalani pemeriksaan MRI. Tidak ada pasien yang mengalami demam neutrofil sehingga semua pemeriksaan pencitraan tersebut sebenarnya tidak direkomendasikan oleh IDSA. Pemeriksaan pencitraan tersebut mengubah diagnosis dan manajemen pada 8 (6.5%) pasien.[10]
Berdasarkan hasil estimasi perhitungan biaya pemeriksaan pencitraan dan kultur darah yang dikeluarkan dalam studi retrospektif ini, ditemukan pemeriksaan penunjang yang kurang bermanfaat ini menghabiskan biaya sekitar $226.9 juta per tahunnya. Sehingga dapat disimpulkan pemeriksaan penunjang pencitraan dan kultur darah tidak terlalu bermanfaat pada pasien selulitis tanpa komplikasi serta menghabiskan biaya yang cukup besar.[10]
Kesimpulan
Pada pasien selulitis tanpa komplikasi tidak perlu dilakukan pemeriksaan pencitraan dan kultur darah untuk menegakkan diagnosis maupun untuk mengevaluasi terapi. Hasil pemeriksaan pencitraan dan hasil kultur darah biasanya jarang mengubah diagnosis atau terapi pada pasien selulitis tanpa komplikasi. Dengan mengikuti rekomendasi dari IDSA ini, maka biaya sistem kesehatan dapat ditekan.